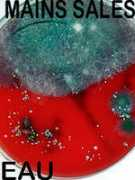
Letinois

First names for Letinois
- Nathan Letinois 2
- Mathilde Letinois 2
- Jacky Letinois 2
- Isabelle Letinois 2
- Haydra Letinois 2
- Gabriel Letinois 2
- Shirley Letinois
- Patricia Letinois
- Pascal Letinois
- Nicolas Letinois
- Michmiche Letinois
- Marvin Letinois
- Martine Letinois
- Klokeliannie Letinois
- Katerina Letinois
- Jean Letinois
- Guillaume Letinois
- Est Letinois
- Eloane Letinois
- Demian Letinois
- Christophe Letinois
- Bruno Letinois
- Brigitte Letinois
- Brice Letinois
- Antoine Letinois
- Anthony Letinois
- Aline Letinois
- Alan Letinois
Typos & Misspells
letinios, lteinois, leitnois, letinoi, letinoisa, letonoos, lettinois, lletinois, letinoise, letinoisi, letinoiso, letinnois
Top Images for Letinois